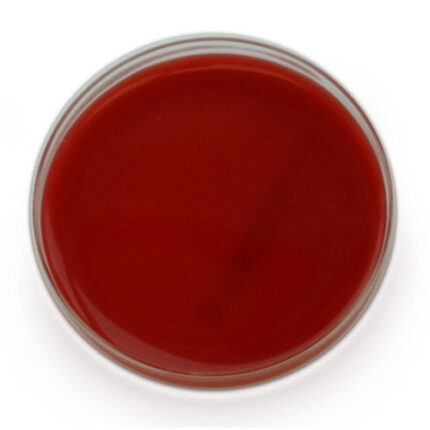

محیط کشت XLD
✔ زایلوس لیزین دئوکسی کولات آگار برای جداسازی و تمایز عوامل بیماری زای روده ای استفاده می شود. این آگار به طور گسترده ای به عنوان محیط افتراقی منتخب برای گونه های سالمونلا استفاده میشود.
دسته: میکروب شناسی
Shipping & Delivery
محصولات مرتبط
محیط کشت مولر بلاد
محیط کشت مولر هینتون آگار
محیط کشت بلاد آگار
✔ محیط کشت بلاد آگار یکی از محیط های کشت غیر انتخابی است که سرشار از مواد مغذی بوده و به همین دلیل رایج ترین محیط کشت مورد استفاده در آزمایشگاه ها است.
✔ در این نوع محیط کشت میکروارگانیسم هایی که به سختی رشد می یابند و همچنین بسیاری از باکتری های بیماری زا به خوبی کشت می شوند. بلاد آگار محیط مناسبی برای کشت باکتری هایی مانند هموفیلوس آنفولانزا، گونه های نایسریا و استرپتوکوک پنومونیه است.
محیط کشت مانیتول سالت آگار
✔ مانیتول سالت آگار برای جداسازی استافیلوکوک ها در محیط آزمایشگاهی استفاده می شود. مانیتول سالت آگار محیط بسیار انتخابی است و نمونه هایی از منابع بسیار آلوده بدون خطر رشد بیش از حد روی این محیط پخش می شوند.
✔ باکتری هایی که در حضور غلظت بالای نمک رشد می کنند و مانیتول را تخمیر می کنند ، محصولات اسیدی تولید می کنند و شاخص pH قرمز فنل را از قرمز به زرد تبدیل می کند.
محیط کشت SIM
✔ محیط کشت SIM مخفف Sulfide Indol Motility می باشد که محیطی بی رنگ ،نیمه جامد وافتراقی و درون لوله ای هست.این محیط کشت برای شناسایی انتریوباکتریاسه مانند سالمونلا و شیگلا، جداسازی باسیل های روده ای و شناسایی میکروارگانیسم های متحرک به کار می رود .
✔ محیط کشت SIM شامل ترکیبات تریپتون ، پپتون، سولفات امونیوم اهن، تی سولفات سدیم، اگار،و بافت حیوانی (برای تامین اسیدهای امینه و مواد مغذی لازم برای رشد باکتری ها) می باشد.اساس تمایز گرم منفی ها در محیط کشت اس ای ام براساس حرکت، تولید اندول و تولید سولفید است.
محیط کشت EMB
محیط کشت شکلات آگار
محیط کشت TSI
✔ محیط کشت TSI مخفف Triple suger iron agar است و محیطی جامد و افتراقی است . برای تشخیص باکتریهای رودهای (خانواده انتروباکتریاسه ) به کار میرود. این محیط کشت به صورت شیبدار و درون لوله ای است.
✔ محیط کشت سیمون سیترات آگار شامل لاکتوز ، سوکروز ، دکستروز ، سدیم کلراید ، سدیم تیوسولفات ، فریک آمونیوم سولفات ، عصاره گوشت ، عصاره مخمر ، پپتون گرانوله گوشتی ، فنول رد ، آگار می باشد.